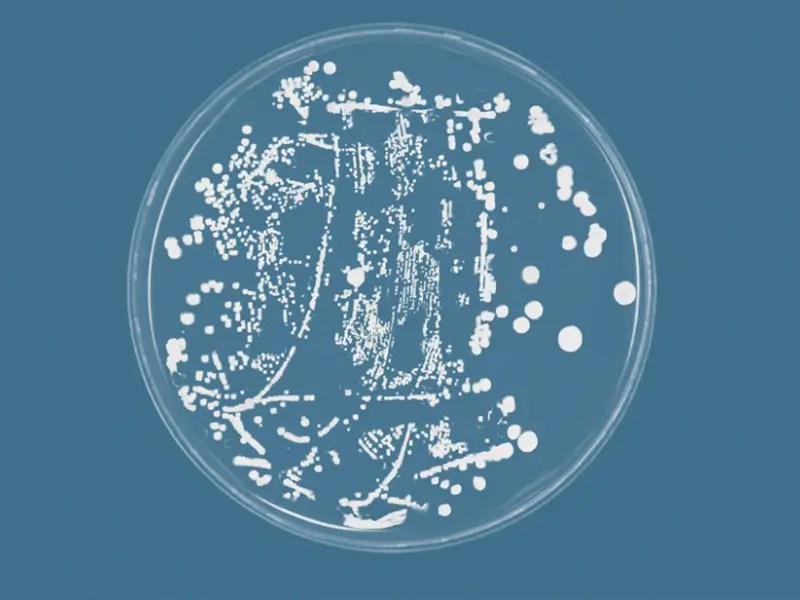

smarter robots. cleaner spaces.
Delivering simple to use and smart UV light robots that are +99.99% effective at reducing bacteria, viruses, and spores.




self-driving UV light robot
This UV disinfection robot completes hospital rooms in as little as 15 minutes with no pre-mapping required. Powerful UV lights targets bacteria, viruses, and other microbes in the air and on surfaces.
A user-friendly screen and mobile app make it easy to use.

simple
- Simple to operate workflow
- Cost-effective
- Low-maintenance

smart
- Self-navigating movement
- AI “Smart Disinfection”
- Advanced safety features

effective
- Works on surfaces + air
- +99.99% effective when used as directed
features + function
powerful UV lights
Eight UV-C lamps deliver 200-280 nm of concentrated irradiation without the harmful O-zone found in other UV disinfection devices.
AI "Smart Disinfection"
The robot detects high-touch objects and concentrates the light on these contamination zones as it navigates around the room.
low maintenance
Easy to replace lamps are effective, practical, and economic. Includes a standard battery and charger that can be plugged into any wall outlet.
touch screen + mobile app
Simply select the disinfection level and deploy the robot. Check its progress and download reports wirelessly from your phone or tablet using our Android app.
autonomous self-driving
Room gets rearranged? No problem, this AI robot navigates in real time without any pre-mapping required.
safety features
Cameras monitor the disinfection zone and shut off the bulbs immediately if a person is detected. Onboard voice commands + LED’s make status updates accessible.

FILL TO SCHEDULE


meet with one of our experts
Schedule a discovery call to learn how adding AI robots into your existing workflow can boost ROI and deliver cleaner, healthier spaces for patrons and staff.
How does UV-C light destroy microbes? 🧐
exploding cell membranes
Microbes, also referred to as pathogens, are tiny living organisms like bacteria, viruses, and fungi that can cause a variety of illnesses. UV-C is a special type of ultraviolet light that damages the DNA and proteins inside these microbes.
When exposed to UV-C light, the rays damage their internal structures causing the protective cell membranes to break apart. This damage makes it impossible for microbes (and spores) to survive or reproduce. The cell-destroying ability of UV-C light is a widely accepted disinfection methods used around the world today.

Manual vs UV Disinfection
Manual cleaning with wipes or sprays is a requirement, but it doesn’t catch everything—especially on high-touch surfaces. In fact, manual cleaning alone leaves up to 50% of bacteria on hard surfaces.
When UV-C light is added, it can cut down remaining germs by an additional 90%. That’s a huge difference when health and safety are on the line.*
*Statistics from Rutala et al., 2013, Infect Control Hosp. Epidemiol.
Real-World Microbiology Studies

adding UV-C to target gram-positive Cocci
Haystack’s Violet UV hospital robot consistently demonstrated a greater than 4-log reduction in bacteria, translating to a bacterial cell survival rate of less than 1 in 10,000.
Wow this works, but is it safe?
Adding UV disinfection is an effective, science-backed way to boost your cleaning routine, however it’s important to remember UV-C light can harm skin and eyes, so it should only run in unoccupied spaces.

What happens if someone walks into the room while the lamps are on?
Our robots are the most advanced UV hospital robot on the market. Simply deploy your Haystack smart robot and exit the room. If a person enters the disinfection zone, the robot will automatically shut off the bulbs for safety and send an alert to the app.

🎯 UV-C works on MRSA,E. coli,C. diff ...and more
MRSA
P. aeruginosa
C. diff
CRE
VRE
C. auris
LET'S GET STARTED
Ready to invest in UV light robots?
Meet with Team Haystack to see how our AI robots can streamline workflows and boost ROI.